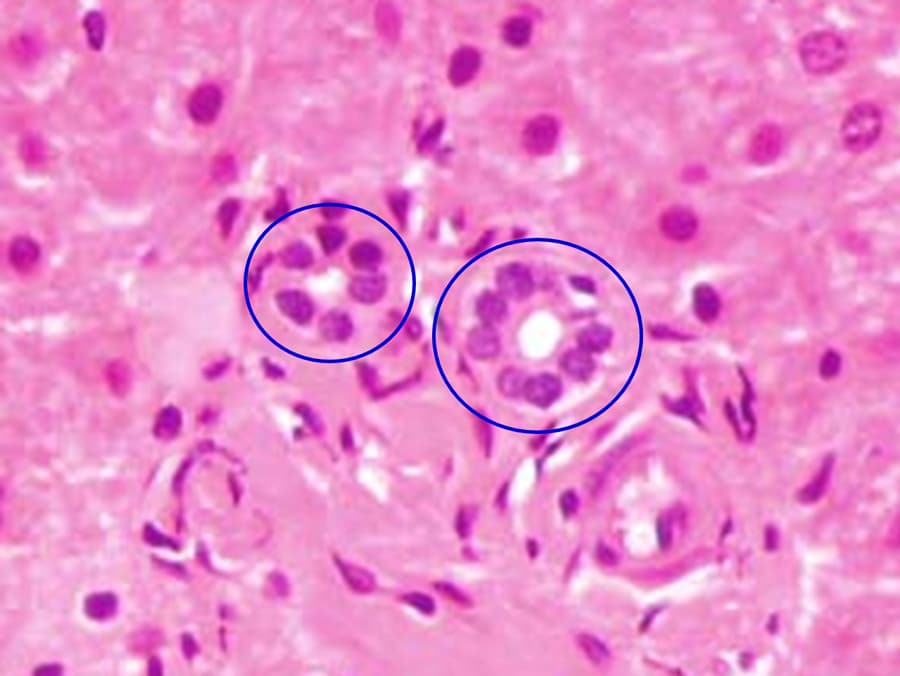

日本原发性胆管炎及其负担的分析
据估计,日本有超过37000人患有原发性胆道胆管炎。被认为是由遗传和环境因素引发的,比如反复出现的尿路感染大肠杆菌如使用指甲油和染发剂,自身免疫性疾病就会看到异常的白细胞攻击肝脏中的胆管,导致胆汁溢出和肝细胞损伤。如果标准的治疗方法不能完全阻止免疫系统的攻击,也会出现疤痕和肝功能衰竭,可能会导致毒性胆汁。幸运的是,全球批准的治疗熊去氧胆酸(UDCA)已被证明对高达70%的患者非常有效,保护了胆管,延长了无移植生存期。但是,尽管这种治疗可以减轻PBC对肝脏的影响,患者仍然会面临瘙痒、疲劳、焦虑、口干和腹痛等症状,以及其他身体、社会、情感和认知方面的影响。这些会扰乱睡眠,损害健康相关的生活质量(HrQoL)。Teikyo大学医学院研究员Atsushi Tanaka教授和他的团队认为,改善症状和HrQoL应该被视为“治疗的一个重要临床结果”。然而,要有效衡量这些改进,需要了解PBC在日本的具体情况,因为不同国家和地区的种族、文化、地理和社会差异可能"严重影响症状和HrQoL "。因此,田中教授和他的团队一直在努力更清楚地了解PBC的病因和主要参与者,以及日本特有的症状和HrQoL负担。

对于在1857年首次描述的疾病,关于PBC的确切原因很少。然而,最近免疫学,遗传学,表观遗传学和分子生物学的进展有助于揭示了PBC的触发,生物标志物和疾病机制。在所有发现中,抗度粒细胞抗体(AMAs)可能是最伟大的一种。其中PBC传统上诊断出在以后和更严重的阶段,研究人员和病理学家现在可以诊断疾病,或者通过识别血液测试中的AMA鉴定患者的患者开发患者的风险。这些人造抗体靶线粒体,其在细胞内进行特定功能。更具体地,AMAS靶向其蛋白质,几乎完全出现在PBC期间。事实证明,肝脏胆管衬里中的染色细胞暴露了结合AMA的线粒体蛋白并火花免疫应答。由于白细胞在这些蛋白质上的工资和肝胆管道衬里,更多的线粒体蛋白质被释放,导致冲突和疾病 - 升级。
估计日本超过37,000人患有原发性胆管炎。
虽然遗传学和表观遗传学在PBC的发展中发挥着重要作用,但环境因素——如重复大肠杆菌感染、频繁染发、涂指甲油、其他化妆品和嚼口香糖都会引发这种疾病。田中教授和他的团队表示,大肠杆菌这些大部分无害的物质含有能引起免疫反应的分子。它们也类似于线粒体中的分子。结果:AMAs和可能的PBC。

中国人民银行在日本
虽然欧洲和北美已经研究了PBC的表现及其对HrQoL的影响,但研究人员尚未确定日本人的症状和影响。事实上,背景差异可以显著改变患者体验疾病的方式。这阻碍了研究人员和临床医生应用国际上获得的见解和优化患者护理。为了解决这个问题,Tanaka和他的团队调查了日本496名PBC患者,研究他们的症状和严重程度。通过翻译标准化和之前验证过的自我报告问卷,研究人员不仅能够看到日本PBC的负担,而且还能将其与之前研究的国家进行比较。
据研究人员称,由于报告瘙痒,疲劳和认知,社会和情绪损害,缺乏黄疸或腹部肿胀,医生认为88%的受访者无症状。事实上,近三分之一的患者表示,“中等”瘙痒“严重”减少了他们的HRQOL,而42%的人说,疲劳和四分之一表达了高社会和认知恶化。然而,大多数关于疾病的情绪紧张,这是一半的受访者感受到。这与英国研究类似,表明疲劳是患者最大的负担,其次是情绪,社会和认知障碍,瘙痒是最不突破的问题。
尽管如此,诊断时的性别和年龄似乎与疲劳有关,在两项研究中,女性和年轻时确诊的人更有可能出现疲劳症状,而较长的随访时间则与瘙痒有关。相反,常用的治疗方法熊去氧胆酸(UDCA)似乎并不能缓解症状的严重程度。
研究结果使研究人员相信PBC症状“主要是由疾病本身决定的,尽管种族、文化和社会差异”,尽管这些因素似乎影响症状的强度。
话虽如此,随着UDCA等药物延长预期寿命,Tanaka和他的团队敦促临床医生“深入询问PBC患者是否有任何症状或HrQoL损伤,即使他们出现‘无症状’”,并找到改善他们生活质量的方法。

替代疗法
UDCA已被证明“完全”有效地治疗大多数患者的PBC,保护肝胆管,帮助患者达到与一般人群相当的预期寿命。但它不能治疗与pbc相关的症状,而且在某些情况下,这种主要安全的药物会导致腹胀、腹泻和便秘。此外,30%的患者对该药表现出“不完全”反应,导致不良预后。现在,研究人员正在寻找其他药物来提高病人的治疗效果。
医生认为88%的受访者无症状,尽管他们报告有瘙痒、疲劳、认知、社交和情绪障碍。
到目前为止,贝莱特表现出了最大的希望。即使在udca耐药患者中,Bezafibrate也显示出了很高的有效性,为成功接受udca治疗的患者提供了类似的预后,与那些对药物没有良好反应的患者相比,“明显更好的结果”。它甚至对治疗pbc引起的瘙痒也很有用。此外,联合用药“显著提高”了PBC患者,特别是早期患者的无肝移植生存率。尽管它取得了成功,但日本还没有批准它用于日常临床使用。

同时,胆汁运输抑制剂和纳尔嘌呤在PBC患者中成功地降低了瘙痒,后者已经批准用于治疗日本住宅患者慢性肝病患者的病症。
虽然这些新药在治疗其他PBC症状和影响方面没有显示出效果,但缓解瘙痒可能是提高HrQoL的第一步,而且希望更多针对其他效果的治疗将会跟进。
不像它的名字那么简单
“PBC”的缩写形式可能很容易说,但解开这种疾病的谜面并非如此简单。直到最近,临床医生还无法在患者出现疤痕和肝功能衰竭之前诊断出这种疾病。幸运的是,田中和他的团队等研究人员的工作帮助阐明了这种疾病,使得更早的诊断、更好的预后,并将重点从治疗疾病转向其产生的症状。他们对日本的关注不仅促进了全球对PBC的理解,而且还可以支持临床医生提高患者的HrQoL。

个人反应
您认为PBC治疗的最佳情况或未来方向是什么?有没有可能在不给患者服用多种药物的情况下控制症状?

